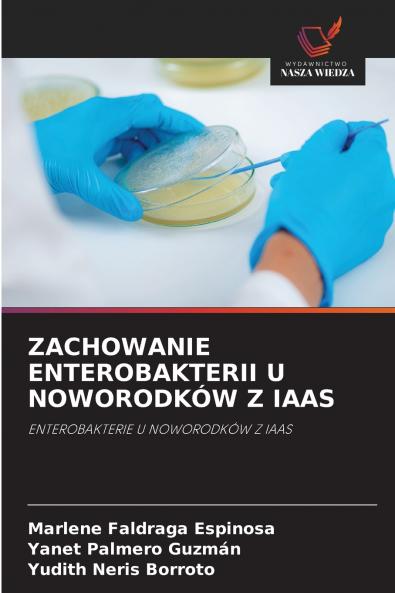
ZACHOWANIE ENTEROBAKTERII U NOWORODKÓW Z IAAS

Paperback
₹5634
₹7427
24.14% OFF
(All inclusive*)
Delivery Options
Please enter pincode to check delivery time.
*COD & Shipping Charges may apply on certain items.
Review final details at checkout.
Looking to place a bulk order? SUBMIT DETAILS
About The Book
Description
Author(s)
Częstość występowania posocznicy noworodkowej związanej z opieką zdrowotną wywołanej przez enterobakterie wzrosła na całym świecie. Przeprowadzono prospektywne podłużne opisowe badanie obserwacyjne w celu opisania zachowania enterobakterii w izolatach z próbek noworodków z IASS przyjętych na oddział neonatologii Szpitala Wojewódzkiego Sancti Spíritus od stycznia 2023 do marca 2024 roku. Pracowaliśmy z 15 próbkami które spełniały kryteria wyboru. Identyfikację gatunkową przeprowadzono zgodnie ze standardami specjalności stosując metodę Kirby-Baüera zgodnie z wytycznymi Instytutu Standardów Klinicznych i Laboratoryjnych oraz Krajowego Laboratorium Referencyjnego ds. nadzoru nad opornością na środki przeciwdrobnoustrojowe w patogenach powodujących ZZOZ. Większość przypadków posocznicy noworodkowej wywołanej przez enterobakterie wystąpiła późno u wcześniaków z niską masą urodzeniową które wcześniej stosowały antybiotyki przy czym Escherichia coli była dominującym zarazkiem a najwyższą wrażliwość wykazywała na meropenem z wyższą opornością na cefalosporyny a większość z nich produkowała BLEE.
Delivery Options
Please enter pincode to check delivery time.
*COD & Shipping Charges may apply on certain items.
Review final details at checkout.
Details
ISBN 13
9786208908584
Publication Date
-31-05-2025
Pages
-56
Weight
-90 grams
Dimensions
-152x229x3.41 mm